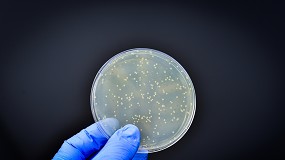

Resultados de la búsqueda "IATA"
La Incubadora IAT organiza un evento sobre los cambios normativos que afectan a la mensajería marítima - 07/10/2024

IAT organiza un evento sobre los cambios normativos que afectan a la mensajería marítima - 07/10/2024: La Incubadora IAT organiza un evento sobre los cambios normativos que afectan a la mensajería
Itene e IATA CSIC lanzan una nueva edición del Máster online en Tecnología de Envases y Embalajes para ayudar a la industria a adaptarse al futuro reglamento de envases - 09/09/2024

IATA CSIC lanzan una nueva edición del Máster online en Tecnología de Envases y Embalajes para ayudar a la industria a adaptarse al futuro reglamento de envases - 09/09/2024: La XVIII
Control de microorganismos patógenos en paletas elaboradas sin sales nitrificantes - 28/09/2025

IATA-CSIC ) Mas allá de este requerimiento legal, la total eliminación de sales nitrificantes en la elaboración de paletas y jamones curados podría constituir una estrategia de marketing que es tendencia
Sostenibilidad del sector aeronáutico: rumbo hacia la reducción del impacto ambiental - 21/10/2025

IATA, que define medidas críticas para alcanzar cero emisiones netas en 2050. A continuación, se resumen las claves de cada línea de acción identificada por la IATA, figura 9. Figura
TK Elevator consigue dos galardones de Elevator World 2025 al Proyecto del Año - 28/01/2025

IATA. A estas cifras hay que sumar los 35,7 millones de pasajeros que apostaron por los barcos como medio de transporte, según la Asociación Internacional de Líneas de Cruceros
Itene e IATA-CSIC lanzan una nueva edición del Máster en Tecnología de Envases y Embalajes para dar respuesta a la creciente demanda de perfiles especializados en esta área - 05/10/2023

IATA-CSIC lanzan una nueva edición del Máster en Tecnología de Envases y Embalajes para dar respuesta a la creciente demanda de perfiles especializados en esta área - 05/10/2023: Itene e IATA
Incluir vegetales deshidratados en el pan mejora sus propiedades nutricionales - 17/09/2024

IATA-CSIC. El LINCE Group, un equipo de trabajo del grupo de Cereales y Productos Derivados del IATA-CSIC, analizó la inclusión de vegetales como espinacas, acelgas, remolachas o cebollas
El salvado de arroz tiene un gran potencial para convertirse en un recurso biotecnológico de alto valor - 08/05/2025

IATA) del CSIC , organismo adscrito al Ministerio de Ciencia, Innovación y Universidades, ha comprobado que este residuo, abundante y poco valorizado, puede convertirse en una fuente sostenible y económica para
Wika presenta el nuevo GA11: análisis de gas SF6 y gases aislantes alternativos con precisión y movilidad sin precedentes - 15/10/2025

IATA). Esto permite transportar el instrumento por vía aérea como equipaje facturado, haciéndolo ideal para intervenciones internacionales. La interfaz de usuario, clara e intuitiva, permite una gestión sencilla e inmediata
Microbiota y epigenética: la inteligencia adaptativa de los organismos del vino - 19/11/2025

IATA-CSIC), se centró en la evolución de las levaduras del vino, desde la domesticación inconsciente hasta los enfoques actuales de evolución dirigida en laboratorio: Sabemos que, a lo largo
Consenso en el sector aeronáutico: la IA nunca podrá reemplazar al ser humano - 04/06/2025

IATA , y Mª Dolores Couso, responsable de Relaciones con Compañías Asistidas, apuntaron en su turno que la seguridad operacional también es fundamental todo lo que sucede en los aeropuertos y la asistencia
Más del 70% de los genes de resistencia a los antibióticos están en la cadena alimentaria - 07/08/2025
IATA-CSIC), las universidades de Nápoles Federico II y Trento (Italia), la Universidad de Medicina Veterinaria de Viena (Austria) y los centros de investigación agroalimentaria FFoQSI (Austria), Teagasc (Irlanda) y Matis
VINEBOX certifica el uso de restos de poda de la vid para la producción de cajas y etiquetas renovables - 28/02/2025

IATA-CSIC), el Instituto Tecnológico del Embalaje, Transporte y Logística (ITENE), y la empresa Athisa, que aporta soluciones para el servicio de recogida y acopio de las podas de sarmiento
Bienestar animal, coproductos y tecnologías emergentes centran el ICoMST 2025 - 02/09/2025

IATA-CSIC) sobre péptidos umami y koku, y la de Patrícia Bernardo (Universidad de Lisboa), que propuso hierbas aromáticas como sustitutos naturales del nitrito. También se exploraron biogeles como reemplazo
Exolum comienza a operar en el aeropuerto Charles de Gaulle con una inversión superior a los 200 millones - 05/06/2025

IATA y miembro del Joint Inspection Group (JIG). Además, desempeña la presidencia del comité de aviación del del Energy Institute y es Miembro Afiliado de ALTA (Latin American and Caribbean
El II Congreso de Seguridad Aeronáutica analizará la relación entre la IA y la seguridad operacional - 15/05/2025

IATA), la Asociación de Líneas Aéreas (ALA), la European Cockpit Association (ECA), el Colegio Oficial de Ingenieros Aeronáuticos de España (COIAE), la Asociación Profesional de Controladores de Tránsito Aéreo (APROCTA
Madrid y Barcelona se sitúan en el top 5 de ciudades europeas más atractivas para invertir en hospitality - 31/07/2025

IATA) se espera un incremento de un 5,5% interanual en pasajeros aéreos en Europa este 2025 está asegurando una estabilidad en los ingresos por habitación disponible, factor que igualmente
FuelsEurope solicita un enfoque equilibrado y competitivo en la revisión del reglamento REACH - 22/05/2025

IATAs) y Nuevas Metodologías Alternativas (NAMs), especialmente relevantes para sustancias UVCB complejas. Flexibilidad normativa con mayor aceptación de exenciones y adaptaciones de los requisitos estándar de información, fundamentadas en la exposición
Valencia se convertirá en el epicentro europeo de la innovación para la monitorización de contaminantes emergentes, la seguridad alimentaria y la química sostenible - 27/05/2025

IATA-CSIC), Centro Tecnológico Itene, Instituto de Química Avanzada de Cataluña (IQAC-CSIC), Instituto de Recursos Naturales y Agrobiología de Sevilla (IRNAS-CSIC), Universidad de Oviedo (UniOvi), University of Gdansk
OBS advierte de la falta de una política europea común que facilite avanzar al sector aéreo - 01/07/2025

IATA declaraba: Todo esto puede complicarse por el nivel cada vez más alto de doble nacionalidad entre los pasajeros y el tráfico de tránsito. Algunas normas de protección de datos
